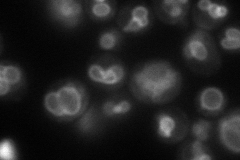
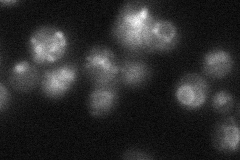

View description
Vacuolar transporter that mediates zinc transport into the vacuole; overexpression confers resistance to cobalt and rhodium
Localization:
Intensity:
Fold change:
Significance:
-
C’ GFP library in SD

below threshold13.82 -
N' NOP1pr-GFP in SD
vacuole membrane112.189 -
N' TEF2pr-mCherry in SD

cell periphery,vacuole membrane121.76 -
N' NATIVEpr-GFP in SD
vacuole membrane29.9279 -
N' TEF2pr-VC and Cyto-VN in SD

vacuole membrane37.1576 -
C’ GFP library in SD+DTT

cytosol13.40.96No -
C’ GFP library in SD+H2O2

cytosol15.831.14No -
C’ GFP library in Starvation Media

cytosol16.431.18No -
C’ GFP library on the background of Pup2-DaMP

below threshold -
C’ GFP library on the background of CCT mutant

below threshold15.48951.1203No
